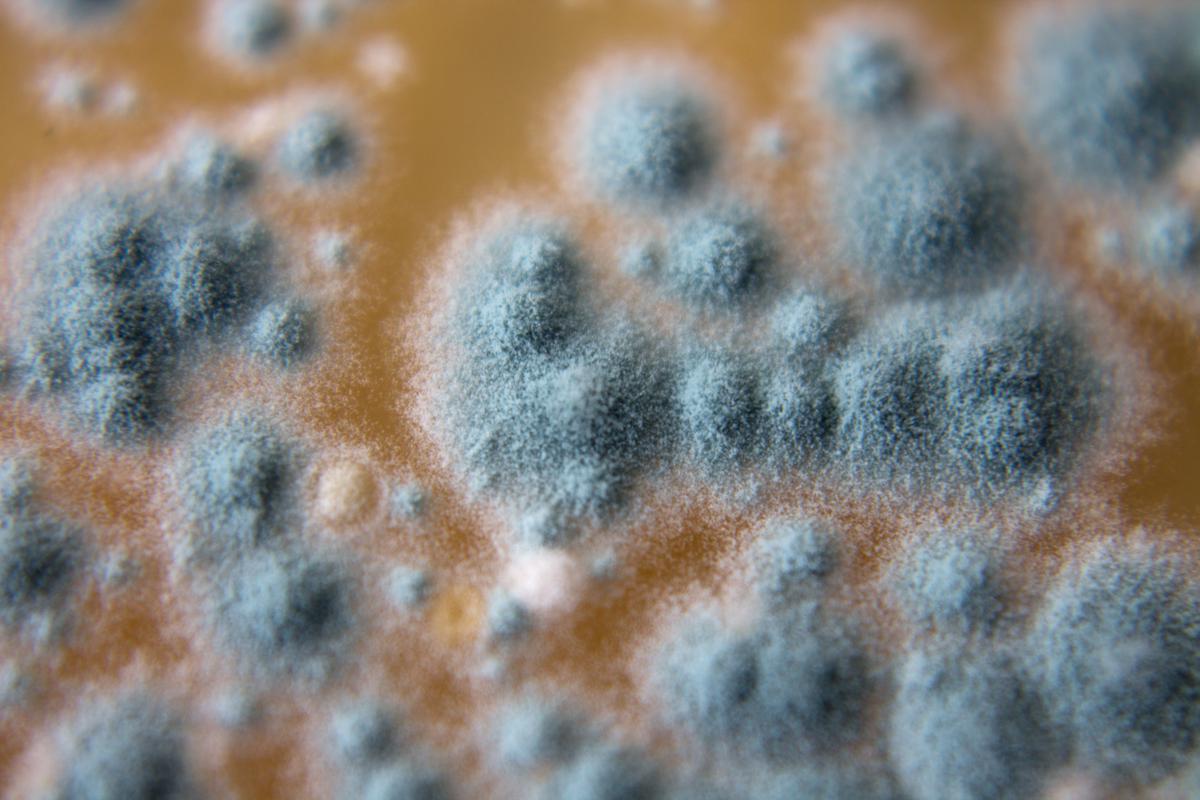
Acremonium is a Toxic Mold You Don’t Want to Befriend
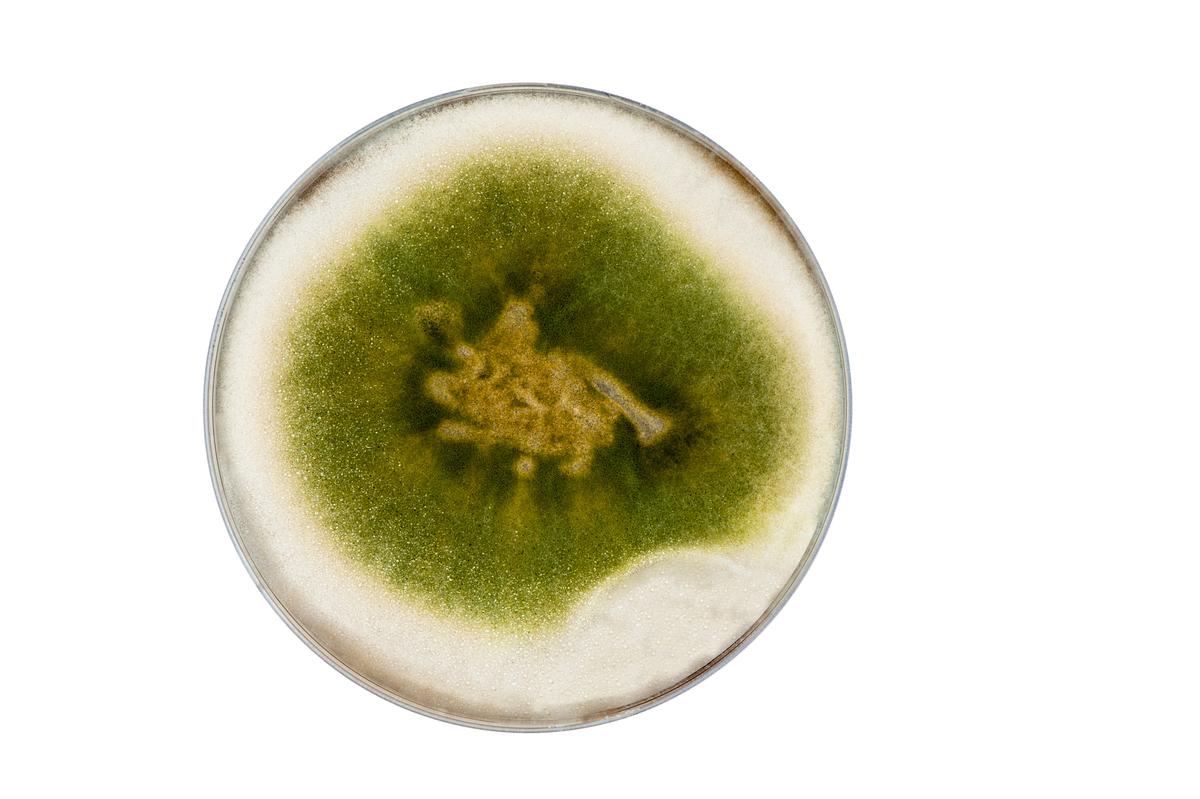
Trichoderma Could be Dangerous For Buildings

Molds are potentially dangerous and toxic fungal species that can grow inside of your home under certain conditions. The reasons for mold growth can be different but once you’ve got it, it’s important to be able to know if it’s dangerous or not. Certain mold species can cause health issues and significant house damage. A common time of year when homeowners notice mold is during the annual spring cleaning. Whenever you do, it’s preferable to deal with it while it is small or at least try to stop it from spreading.
There are three types of mold: allergenic, pathogenic, and toxigenic. Identifying mold types can be tricky, so don’t rush into trying to clean it out before figuring out if it’s dangerous. To know for certain whether it’s mold or not, you can call a home inspector and have your house checked. It wouldn’t hurt to ask the inspector to check your house for asbestos as well.
All molds have a specific description, color, and a recommended method of dealing with them. Certain ones can be removed without any help, but you have to be ready to call the mold removal professionals because they could be harmful to your health.

comments